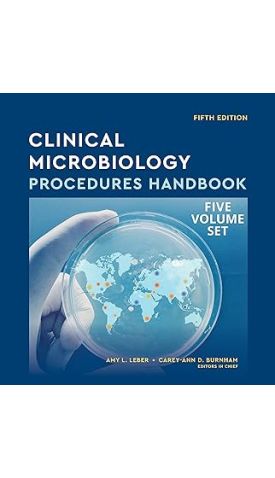
main product photo

אנו משתמשים ב-Cookies כדי לשפר את החוויה שלך. כדי לקיים ההנחיה החדשה של e-Privacy, עלינו לבקש את הסכמתך להגדיר את ה-Cookies. קבלת מידע נוסף.
Clinical Microbiology Procedures Handbook, Multi-Volume 5th edition
Gold Standard consensus-based procedures from the experts.
The Clinical Microbiology Procedures Handbook, 5th edition, provides those engaged in microbial analysis of clinical specimens with procedures for the detection, identification, and characterization of microorganisms involved in human infections. This unique and valuable collection of step-by-step descriptions of the numerous testing modalities used in the clinical microbiology laboratory was written and edited by highly knowledgeable laboratorians. The 5th edition features two new sections, one on blood cultures and one on MALDI-TOF MS, and the sections on molecular diagnostics, virology, and serology were extensively revised and updated. Presented over multiple volumes, this handbook enables laboratory staff to perform all analyses, including appropriate quality control recommendations, from the receipt of the specimen through processing, testing, interpretation, presentation of the final report, and subsequent consultation.

Login and Registration Form